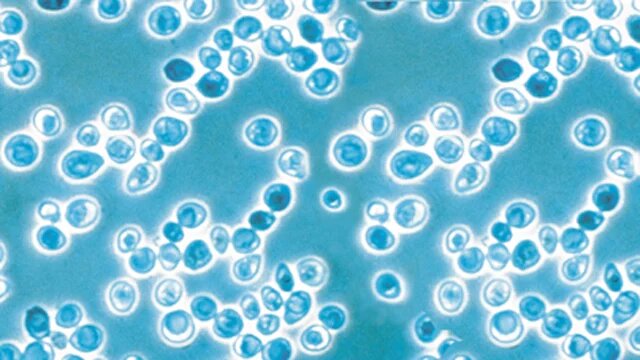

Craft brewing
Añada nuestra experiencia y equipo de elaboración de cerveza profesional a su energía en la elaboración artesanal. Alfa Laval puede ayudarlo en su viaje de elaboración artesanal y a superar desafíos. ¿La necesidad de una calidad constante debe ser un objetivo de producción o podría estar haciendo algo mejor? Tenemos el equipo de elaboración artesanal adecuado, así como la experiencia, el conocimiento y la pasión compartida para ayudarlo.
Cervezas increíbles y sobresalientes
- Soluciones para todos los cerveceros de la mano de quienes conocen su oficio.
- Historial comprobado de rendimiento mejorado y menor consumo de agua y energía
- Flexibilidad para permitirle aprovechar rápidamente las nuevas tendencias en la elaboración artesanal
- Una red de servicio global de especialistas en elaboración de cervezas artesanales para brindarle ayuda con equipos de elaboración de cerveza
Proceso de elaboración de cerveza artesanal
Elimine los desafíos en el proceso de elaboración de la cerveza con nuestro equipo de elaboración de cerveza
La mejora de las operaciones es algo cotidiano para los productores de cerveza, desde la fábrica hasta el envasado. Las mejoras en aumento en el rendimiento del mosto, la pérdida de cerveza o el consumo de agua pueden representar ahorros significativos a largo plazo. Vea cómo nuestra experiencia en el proceso de elaboración de la cerveza, las soluciones y los componentes individuales de cada bloque de proceso ayudan a evitar y superar problemas comunes en el proceso de elaboración de la cerveza.
Fábrica de cerveza
Recupere el mosto, reduzca los residuos, ahorre energía y mejore la eficiencia e higiene de su fábrica de cerveza.

Sección fría
Recupere cerveza, reduzca el tiempo de fermentación y maduración, mejore la manipulación de la levadura, tome muestras y mucho más.
Filtrado y tratamiento
Evite los desperdicios, mejore la calidad de su cerveza y diversifique sus productos

Preparación de líneas y limpieza
Optimizar la limpieza y preparación de líneas.

Equipo para la elaboración óptima de cerveza artesanal
El oficio de hacer cerveza combina procesos complejos con un arte creativo. Cerrar la brecha entre la teoría de la elaboración de la cerveza y la elaboración práctica artesanal proviene de la experiencia para detectar signos de problemas y saber cómo responder ante ellos. Aquí es donde la combinación de experiencia puede generar beneficios que se extienden desde la sala de cocción hasta el envasado. Los problemas pueden controlarse y evitarse, dado el equipo de elaboración de cerveza correcto y la aplicación correcta. Consulte nuestro conocimiento de procesos y soluciones de elaboración artesanal.
Clientes felices
Compañía cervecera de Boston
Una de las primeras cosas que instalamos fue un separador Alfa Laval Brew. Alfa Laval también estaba dispuesto a asumir gran parte de la gestión del proyecto. Gestionaron con éxito todo el proceso y estuvieron disponibles durante todo el proceso con apoyo técnico.
David Grinnell, Vicepresidente de operaciones de elaboración de cervezas, Compañía Cervecera de Boston, USA
Harpoon Brewery
El sistema Iso-Mix nos proporciona un método rápido y constante para ajustar el contenido de CO2 y la gravedad, y brinda otra serie de ventajas que reducen tanto la intervención de mano de obra como el riesgo de retrasos en las operaciones de embalaje.
Al Marzi, Vicepresidente y director general de elaboración de cerveza, Harpoon Brewery, USA
Amager Bryghus
Con solo una unidad compacta de Brew 80, puede permitirse ser más creativo. Para experimentar con sabores, solo le limitará su imaginación. Este equipo ha demostrado ser más versátil de lo que habíamos imaginado, y da un gran impulso a nuestro enfoque creativo, no convencional para la elaboración de cerveza, y productos que realmente destacan en un mercado abarrotado.
Morten Valentin Lundsbak, Fundador, Amager Bryghus, Copenhague, Dinamarca
Rebellion Beer Company
Creo que la elaboración artesanal en una escala relativamente pequeña, como lo hacemos nosotros, sigue siendo un arte tradicional que crea cervezas de carácter distintivo utilizando los métodos tradicionales de elaboración de cerveza, pero junto con elementos de la tecnología moderna, como el Brew 80.
Copropietario Mark Gloyens, Rebellion Beer Company Ltd. Marlow, Buckinghamshire, Reino Unido
Cuando la calidad es lo primero
Descubra soluciones bien diseñadas para cerveceros artesanales.
